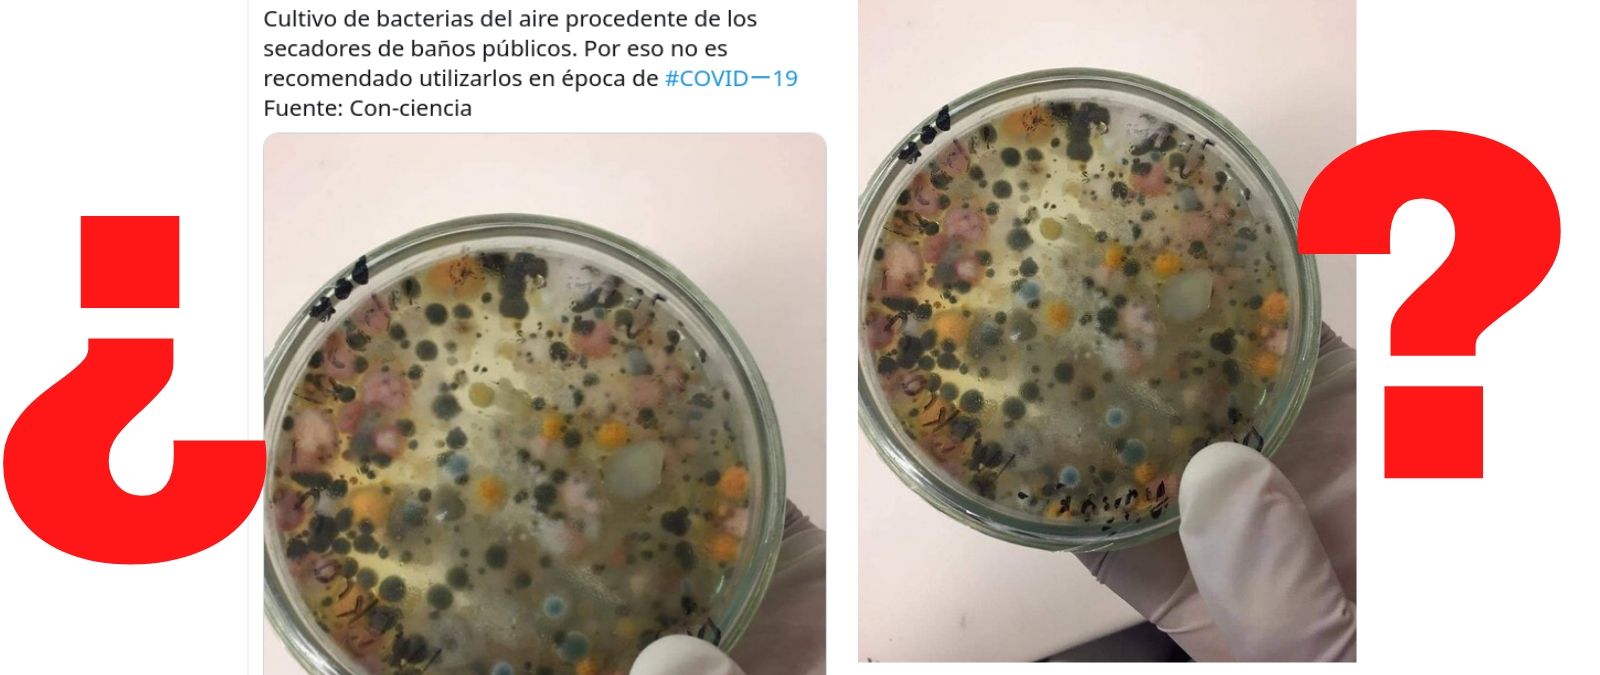

La imagen de un cultivo realizada en una placa de Petri con el aire de los secamamanos de un baño público se ha viralizado como argumento para no usarlos durante la pandemia de la COVID-19. ¿Pero qué nos dice realmente esta imagen?
Lo primero es aclarar que los virus, tampoco el coronavirus SARS-CoV-2, no crecen en placas de Petri. "En ese medio sólo crecen bacterias, levaduras y hongos, que son organismos vivos que no necesitan de un hospedador para vivir. Sin embargo, los virus necesitan de células para infectar y multiplicarse", explica a Maldita.es la viróloga Sonia Zuñiga, investigadora de coronavirus en el Centro Nacional de Biotecnología.
"Si los secadores de manos no están correctamente revisados e higienizados, al usarlos se puede producir una contaminación de las manos con más bacterias y hongos de las que hay habitualmente en la flora bacteriana de la piel", aclara Zuñiga, que señala que "habría que ver cómo se ha hecho ese cultivo", que incluye tanto bacterias como hongos.
Debido a que el ambiente está lleno de bacterias y hongos, "si dejas una placa de Petri encima de tu mesa abierta cinco minutos y la metes en una estufa a 37ºC en uno o dos días la tendrás llena de bacterias y hongos. No creo que un secador esté más contaminado que el fregadero de nuestras casas o el lavabo", argumenta a Maldita.es Pepe Alcamí, virólogo del Instituto de Salud Carlos III.*
Como explica también a Maldita.es Víctor Jiménez Cid, catedrático de Microbiología de la Universidad Complutense de Madrid y miembro de la Sociedad Española de Microbiología, "el aire que entra en el secamanos se filtra y como en los baños suele haber humedad, esos filtros son cultivos para bacterias que pueden ser patógenas o no, ya que no se suelen cambiar los filtros".
Pero Jiménez Cid aclara que respecto a la transmisión de este u otro virus "no creo que tenga nada que ver los secamanos. El riesgo está en las cosas que tocan muchas personas y no se higienizan como puede ser el botón del secamanos". Para Jiménez Cid, la imagen de la placa Petri "induce a error al insinuar que el secamanos favorece el crecimiento del coronavirus".
La OMS recomienda usar papel desechable
Como ya os contamos, la OMS recomienda tras lavarse las manos secarlas con toallas o papel desechable. Respecto al coronavirus, desde la OMS siempre se ha recomendado secar las manos con papel o toallas desechables, en vez de con secadores de manos, pero por higiene general más que porque sean fuente de contagio del virus, señala Zuñiga. Los secamanos son más higiénicos que las toallas de tela pero menos que las toallas de papel, añade Víctor Jiménez Cid.
Este texto sobre Facebook ya fue desmentido por Snopes en 2012 , fecha desde la que al menos desde que circula este mensaje. The Guardian y The Telegraph también desmintieron esta cadena en 2016.
*Primera fecha de publicación de este artículo: 15/07/2020.
*Actualizado el 15 de julio con los comentarios de Pepe Alcamí.